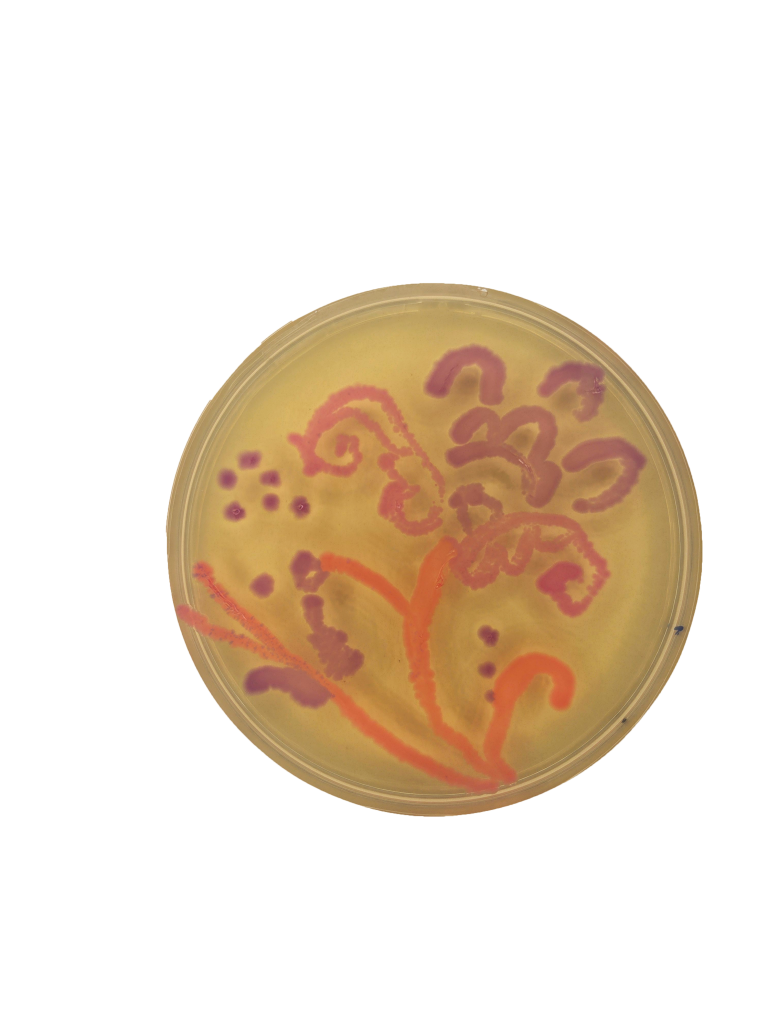
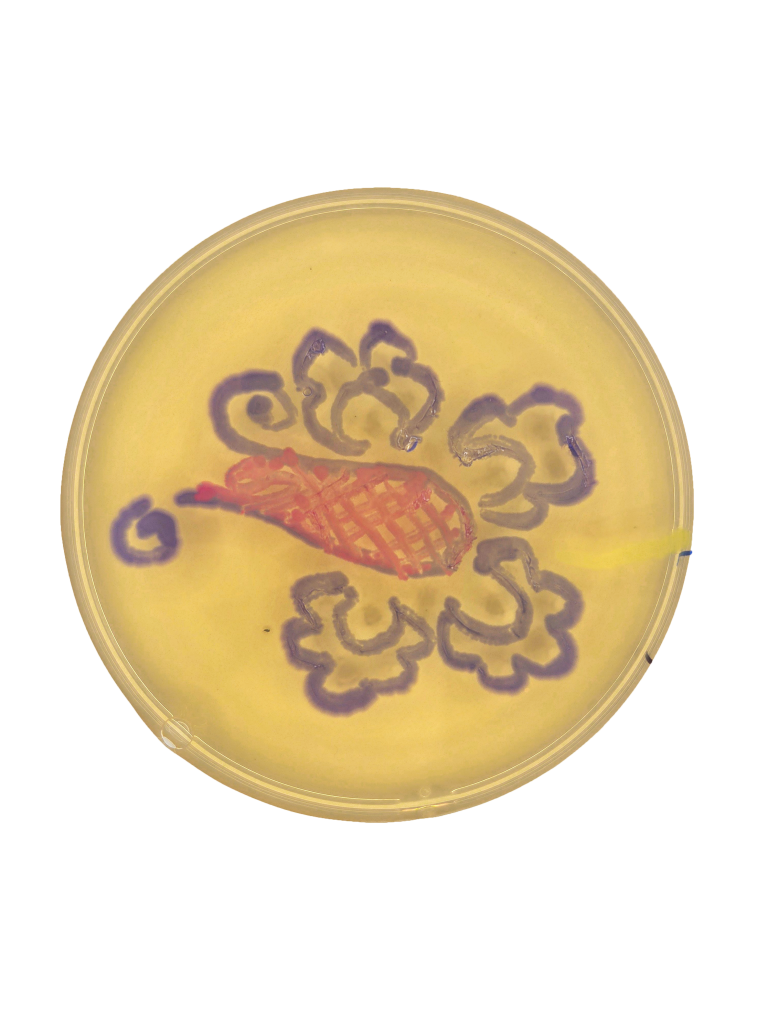
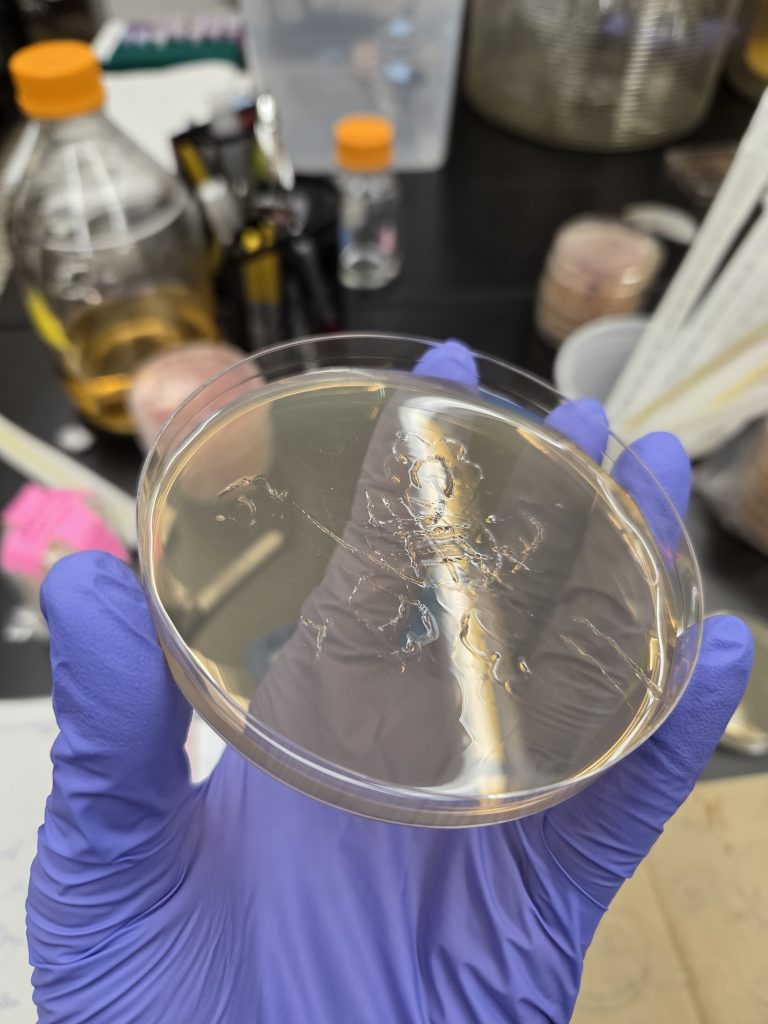

Maria Barceló Tous, IS, 2027
“Soy como un árbol, con las raíces en un país y las ramas abiertas al mundo” – Eduardo Chillida
(I am like a tree, with roots in a country and branches open to the world.)
Maria Barceló Tous is an artist in evolution from Mallorca, Spain. She is majoring in interdisciplinary sculpture at the Maryland Institute College of Art. Maria has participated in exhibitions internationally and has been published by the Acuarium of the Pacific. Her art is mostly inspired by Spanish folklore, nature, and the relationship between emotions and the body. Maria is currently experimenting with biomaterials, and learning how to mix her weaving skills with wood and unconventional materials.
Collaboration between generations
Stencils of Mallorcan embroidery by Antonia Barceló Oliver, LB agar plates, gloves, tape, genetic engineered E.Coli.
This project is a collaboration between living and deceased kin. It utilizes Mallorcan embroidery patterns that were used in previous generations. This decorative art is a depiction of nature in an abstract way. Genetic engineered E.coli was used to draw nature through traditional abstraction, thus innovating within the tradition and collaborating with family and nature.

Process
The first attempt to modify the DNA of E.Coli didn’t work. In the first attempt, white cells grew, which led us to deduce that two destination vectors had merged because there were so many of them.
In the second attempt, we changed the ratio of the mixture, and I was able to create the pink, orange, and purple colors.
I used toothpicks and different plastic lab loops to draw with the cells into the agar plates.
Learn More
Instagram: mbarce_art
Website: Mariabarcelotous.com